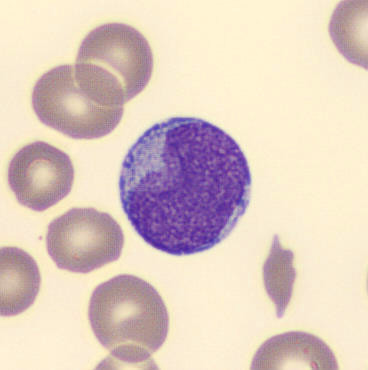
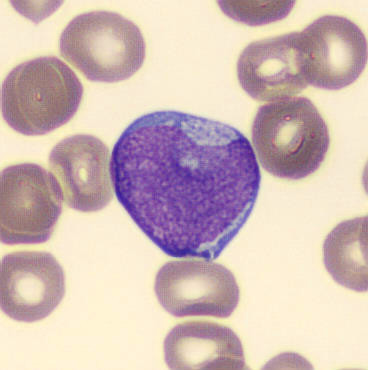
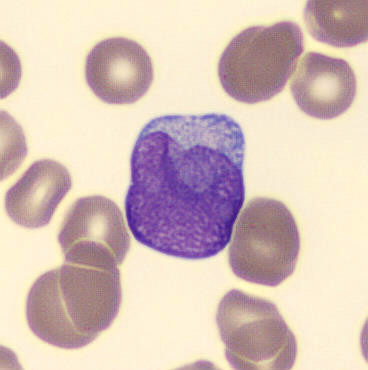
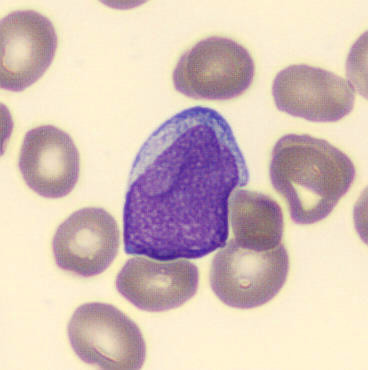
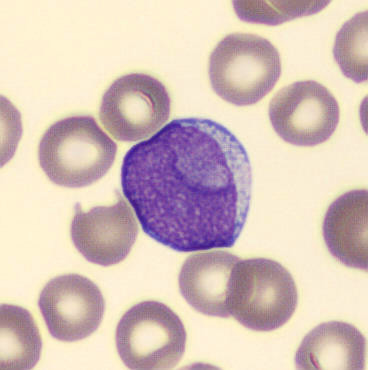
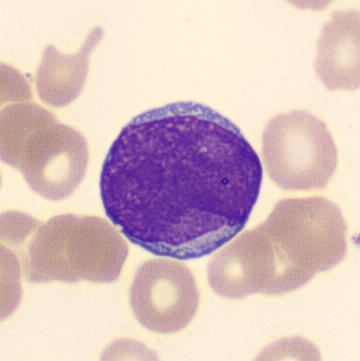
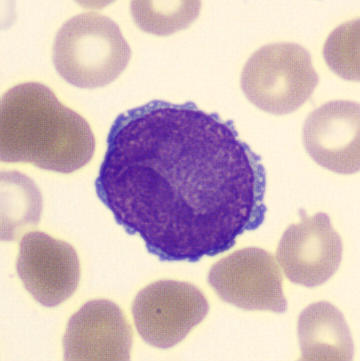
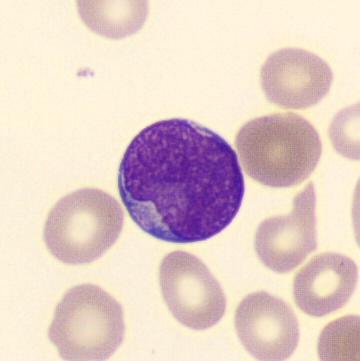

Cuplike
Synonymes: cup like, cup-like
Les blastes en forme de coupe sont des blastes anormaux dont le noyau présente une invagination profonde en forme de bol (en forme de coupe) ou une zone nucléaire étendue et diffuse. On les observe principalement dans la leucémie myéloïde aiguë (LMA), en particulier dans les sous-types présentant des mutations NPM1 et une négativité du CD34. La présence de blastes en forme de coupe est un indice morphologique de la LMA mutée NPM1. Cette anomalie nucléaire est souvent plus évidente dans le sang périphérique que dans la moelle osseuse.